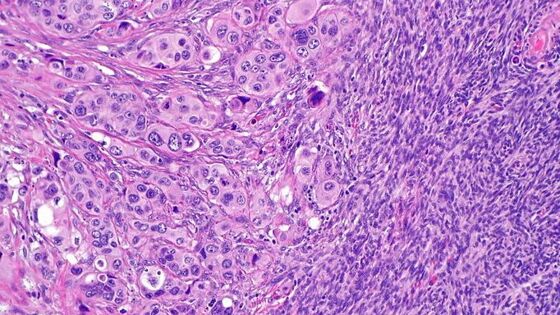

Международная команда ученых выяснила, что заставляет раковые клетки распространяться по организму на очень ранних стадиях развития первичной опухоли. Исследование опубликовано в журнале Nature. Опухолевые клетки могут переходить из одной части тела в другую. Такие перемещения клеток из первичного очага болезни называются метастазами. Именно они являются основной причиной смерти от онкологических заболеваний. По оценкам экспертов, 5% больных раком по всему миру имеют метастазы, но не имеют первичной опухоли. Теперь ученые из Школы медицины Икан на горе Синай (США) и Регенсбургского университета (Германия) установили механизм раннего метастазирования. В своем исследовании медики обнаружили, что у самок мышей, больных раком молочной железы, в 80% случаев метастазы возникали из «ранних» раковых клеток, а не из зрелых опухолей. Ученые выяснили, что в этом процессе принимает участие мембранный белок HER2, повышенная активность которого увеличивает прогрессирование рака молочной железы, а также ген-супрессор опухолей р38, чьи экспрессируемые белки мешают клетке превратиться в опухолевую. «Включение» HER2 и «выключение» р38 провоцирует эпителиально-мезенхимальный переход, которым сопровождается развитие опухоли. Эти процессы способствуют тому, что раковые клетки через кровь покидают молочные железы и начинают свое «путешествие» в легкие, костный мозг и другие органы. Ученые смогли наблюдать этот процесс в трехмерных культурах клеток – модели, имитирующей условия живого организма. По словам медиков, их исследование добавило очередную трудность к борьбе против рака, однако открытие ученых может помочь придумать способ, который остановит процесс метастазирования.